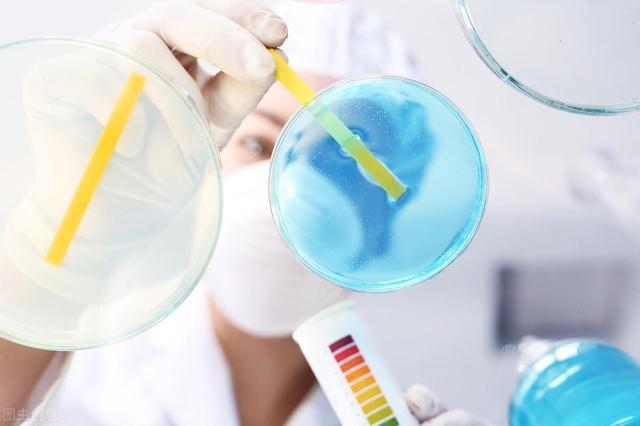
孕酮低肚子疼见红还有必要保胎吗,怀孕初期孕酮低见红了什么情况

中午吃过饭,刚躺下准备午休,电话铃声响起,一看是表姐的来电。按下接听键,问道:“姐,有啥事?”。
表姐说道:“弟啊,老二丽丽这不刚怀孕两个月,平时一直正常啊,今天上午没啥事,我陪着她逛了逛街,走的路也不多呀。这不,回来后,丽丽上洗手间发现见红了,这可该怎么办呢?”

丽丽是表姐的二女儿,刚新婚不久。我说道:“姐,这样啊估计是先兆流产的症状,你们这样,现在去医院,到医院里,医生会让你们先检测一下孕酮,看看怎么样,如果异常的话,医生会提出相应的指导意见的。”
表姐听完,马上说道:“好,我们这就去。”挂了电话,想到大多数的孕妈对于孕酮的了解很少,碰见孕早期见红会非常害怕与恐慌。所以,今天,就和各位新手孕妈们一起来了解孕酮的相关知识。

01 什么是孕酮
孕酮又称为黄体酮,是由卵巢黄体分泌的一种天然孕激素。在体内对雌激素激发过的子宫内膜有显着形态学影响,主要是在怀孕的时候让胚胎着床生长的激素,是维持妊娠所必需一种激素。
黄体酮对女性的影响非常重要,它可以降低体内的孕酮水平,从而导致不孕不育,有时还会影响妇科生理功能,出现功能性子宫出血,先兆性流产,习惯性流产,经前期综合症等。维持妊娠所必需的。

02 孕酮的作用
孕酮有免疫保护,抑制免疫反应的作用。有研究将某种肿瘤细胞植入动物子宫内,只有在注射了孕酮的动物,细胞才不被排斥,并向子宫壁植入,说明孕酮可抑制免疫反应。这也能说明,当女性在正常妊娠时,孕酮增加,能防止胚胎被母体排斥而维持妊娠。孕酮不足时,可能使胚胎被母体排斥而流产。
除了具有免疫保护的作用外,孕酮还有促使胚泡着床,抑制子宫收缩,起到保胎的作用。

03 孕酮的正常值
研究认为孕妇体内孕酮降低导致先兆流产、难免流产(即不可避免流产,一般多由先兆流产发展而来,但阴道流血更多,阵发性腹痛更加剧烈,或出现阴道流水),需外源补充孕酮来维持早孕。研究发现孕酮值≥25ng/ml为正常,孕酮值在15-25ng/ml,提示黄体功能不足,需要黄体酮治疗,成功率较大。孕酮值≤15ng/ml则治疗意义不大,需尽早终止妊娠。
04孕酮检测的必要性
孕酮是维持妊娠所必须的激素,也是支持胎儿早期生长发育的重要激素,足量的孕酮能够保证子宫内膜功能的正常,促进胚胎的生长发育,还具有抗排异和抑制子宫收缩的作用,从而保证胎儿在子宫内能够顺利地生长发育,直至足月。现在,因为妊娠期孕酮分泌不足引起的流产有很多,而孕早期检查孕酮能够了解体内孕酮分泌状况,比如说出现孕酮分泌不足时可以采取补救措施通过治疗恢复正常水平。

05 孕酮低怎么办
女性在怀孕以后,体内的激素发生了改变,绒毛膜促性腺激素、孕酮、雌激素都会有所升高,这些激素都是胚胎自身分泌的。
当孕酮检测水平比较低,考虑胚胎不稳定。胚胎分泌孕酮低,就要考虑胚胎是否有异常,如果胚胎质量不好,是会自然淘汰或者选择性淘汰的。当然,发现孕酮偏低,建议积极地给予孕酮保胎治疗。主要运用的就是孕酮类制剂,如黄体酮注射液、地屈孕酮片、雪诺酮阴道栓等。